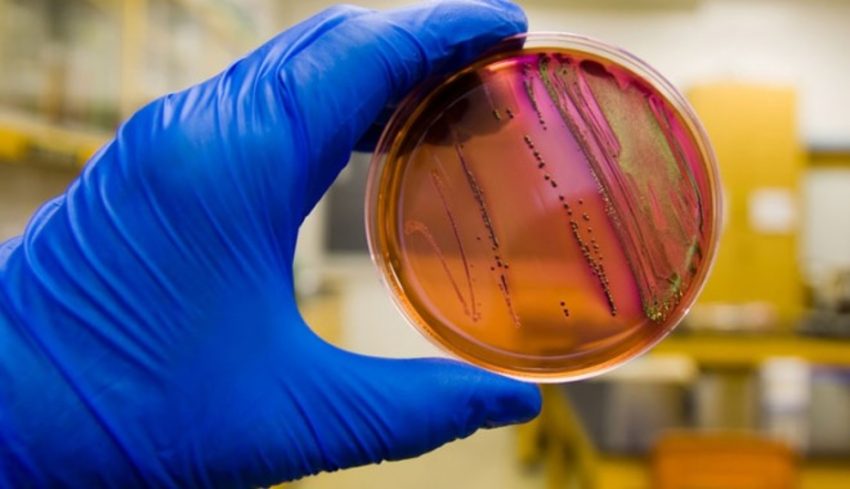
Salmonella Testing Market

Salmonella is a bacteria that causes foodborne illness. It can be severe for infants, older adults, and people with weakened immune systems. Stool samples are the most common clinical materials tested for Salmonella, whereas ready-to-eat foods and animal feces are also tested. Microbiology laboratories culture the sample and perform serotyping to identify the strain. Traditional methods rely on a multistep culture-based approach to detect Salmonella Testing in food samples. Initial identification is based on colony appearance and followed by confirmation via biochemical testing such as negative urease reaction, lysine decarboxylase test, fermentation of glucose, and H2S production. A number of rapid and semi-rapid tests are available that offer the potential to reduce the overall analysis time, particularly when compared with ISO 6579:2002 standard methods. These tests typically require a one or two-step enrichment and provide results in as little as 20 minutes following the standard ISO 6579: 2002 enrichment protocol.
As Salmonella Testing generates vast amounts of data, the integration of big data and predictive analytics will become increasingly crucial. By harnessing these technologies, researchers and food safety authorities can identify patterns and trends, predict potential outbreaks, and proactively implement preventive measures. This proactive approach will be instrumental in ensuring early detection and containment of Salmonella contamination. The global Salmonella Testing Market size was valued at US$ 2.91 billion in 2023 and is expected to reach US$ 4.91 billion by 2030, growing at a compound annual growth rate (CAGR) of 7.8% from 2023 to 2030.
Another promising new approach that uses phage reporter technology to rapidly detect Salmonella is Salmonella Testing. This novel method leverages the sensitivity of engineered NanoLuc-expressing bacteriophages that target Salmonella. Traditional methods often require pre-enrichment of samples in non-selective media such as buffered peptone water for 18 hours. Then, the isolate is cultured on selective agar plates, which can delay the result. A bacteriophage assay with luciferase reporter phages reduces the enrichment and identification times by enabling Salmonella to be detected from raw products in less than 2 hours. This assay has demonstrated minimal false positive results when compared to conventional testing methods including PCR and latex agglutination.
Once a sample is identified as containing Salmonella, further confirmation, and serological identification can be performed using classical biochemical tests and polyvalent antisera for Flagellar and Somatic antigens. This information can then be used to identify the serotype of Salmonella. Salmonella infection can cause gastroenteritis ranging from mild to severe with symptoms such as fever, vomiting, and diarrhea. In some cases, Salmonella infection can also lead to sepsis. The global Physician Office Diagnostic Market size was valued at US$ 104.47 billion in 2023 and is expected to reach US$ 258.21 billion by 2030, growing at a compound annual growth rate (CAGR) of 13.8% from 2023 to 2030.
Salmonella is found in the feces of people and animals, as well as in raw meats and poultry, unpasteurized milk, eggs, and seafood. Infection often results in diarrhea that can last up to seven days and is more likely in children, the elderly, or those with weakened immune systems. Rarely, infection can lead to severe, sometimes fatal illnesses such as typhoid fever so Testing is a must. Most Salmonella Testing is done using traditional culture methods that involve serial enrichments and phenotyping. This process can take up to five days and requires pure cultures. A new approach to detection uses a single-stranded nucleic acid, called an aptamer, which can capture and concentrate Salmonella in samples. These aptamers are similar to antibodies, whereas they have the advantage that they are easier to synthesize and provide more consistency from batch to batch. They are also less expensive than antibodies and more accurate.
Scientists are working on a variety of methods that will speed up Salmonella Testing without compromising sensitivity. These include using luciferase reporter bacteriophages, engineered to infect Salmonella and produce a bioluminescent signal. This is a promising approach that may allow food processors to lower their product hold times without risk of contamination, as well as reduce the amount of time required for testing. West Lafayette scientists have created a scanner that can identify bacteria, including Salmonella, much faster than traditional techniques. The device, called BARDOT, scans a plate of bacterial colonies and identifies them based on their unique arrangement of rings and spokes, a pattern that resembles the iris of an eye. Public health laboratory experts subtype Salmonella by serotyping to help find and track outbreaks. Finding a group of infections with similar profiles can help epidemiologists link illnesses to specific food sources. These data are compared with the results of whole genome sequencing to identify the source of the outbreak.